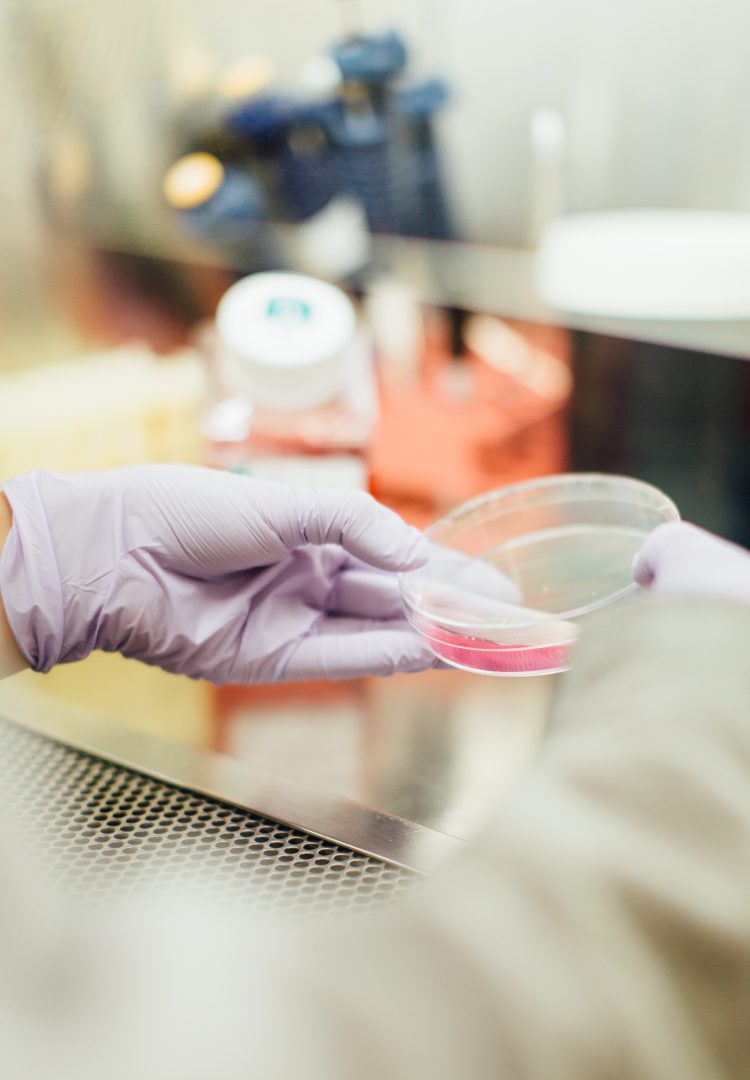

Are you looking to…
- get into the Asian market and frustrated by the cultural gaps?
- build a company and need help to prepare a Business Plan?
- assess which kind of investment is most suitable for you?
- prepare a winning presentation to potential investors?
- raise capital or considering M&A?
- progress with your design and hesitating how?
- invest and need to conduct professional Due Diligence?
- expend your business?

We can help by…
- bridging the gaps between East and West.
- working on your Business Plan together.
- analysing the financial situation and alternatives, and guide you to the best solution.
- create a winning pitch.
- finding appropriate investment and suitable M&A partner and facilitating the process.
- top tier system engineering.
- conducting professional Due Diligence, based on your preference.
- Business Development.

About Us
No need to re-invent the wheel. Build your success with the experts' experience!
Iridium consultancy strives for the best to enable you to access the expertise you need for growth in an affordable and scalable way.
Superior corporate development services for start up and life science companies
Our experience - Your success! ™
About UsContact Us
Get in touch for more information
P.O. Box 5474 Herzliya 4615302 Israel

